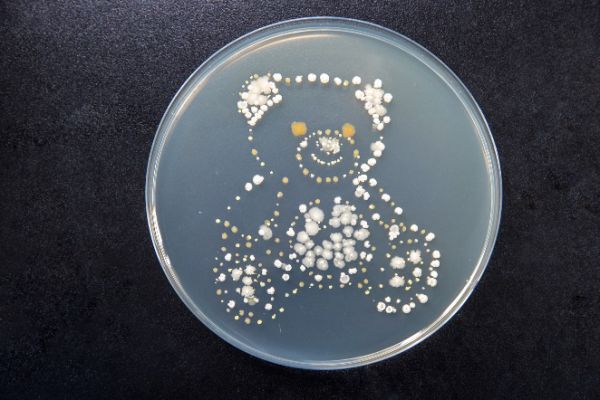

深圳家庭健康“宝”典,致敏主因并非尘螨本身
作为一线城市外来人口占比最高的城市[ 第一财经报道《一线城市外来人口解析:上海数量最多,深圳占比最高》:https://www.yicai.com/news/5377967.html。],深圳的人口出生率超全国平均水平一倍[《深圳2019》统计年鉴:据统计,2019年深圳移民人口达849.1万人,出生率持续超过20‰,超过全国平均出生率的一倍,二孩率高达54.6%。]。父母们在打拼之余需要在陪伴与呵护孩子健康成长上花费很多时间与精力。而深圳高温高湿的气候容易导致尘螨滋生。除螨被视为家庭清洁中重要的一环,但父母易忽视的是,主要致敏原是尘螨分泌物、排泄物及残肢,而非尘螨本身。戴森消费者调研报告显示,定期进行深度清洁已是宝爸宝妈们的普遍选择[ 戴森2019年《地板清洁产品消费者行为态度洞察报告》。]。繁忙的工作之余,一款性能卓越、吸力强劲的吸尘器,能够高效深度清洁居家环境,清除尘螨及其带来的潜在隐患,更好呵护宝宝的生活环境。
什么才是致敏主因?
为深度了解深圳消费者的家庭清洁困扰,戴森委托专业实验室[ 检测机构:上海枫林医药医学检测有限公司,报告名称:《灰尘过敏原检测报告——深圳》,报告编号:202008180003。]从深圳真实家居环境中收集灰尘并进行研究分析。在一户双职工二胎家庭中,研究人员从爬行垫、积木桌、毛绒玩具、床褥、沙发等处都发现了尘螨相关过敏原[ 指尘螨排泄物、花粉、霉菌、细菌、毛发等。],细菌浓度高达7.00×106CFU/克灰尘4,在所有检测灰尘中排名第一4。
实验室报告4指出,造成这一现象的主要原因是深圳高温高湿的气候易导致尘螨滋生。深圳年均温度约在22℃-28℃,年均湿度约在70%-80%。螨虫最适宜生存的温度是22℃-30℃,湿度70%-80%,与人类适宜的环境非常相似。螨虫大量存在于床垫、地毯及各种家居织物上,以人类和动物脱落的皮屑角质蛋白为营养来源。尘螨的分泌物、排泄物及残肢可以引起多种过敏性疾病,成为日常生活中看不见的“共生生物”及致敏主因。
对于格外关注居家环境与宝宝健康的家庭来说,不能忽视主要致敏原——尘螨的分泌物、排泄物及残肢。中国科学院先进技术研究所中心主任(驻广州)的陈贤帅教授表示:“尘螨相关过敏原在家庭环境中通过空气传播,可出现打喷嚏、气喘、咳嗽、流涕、起疹等症状,对呼吸道脆弱、皮肤娇嫩的宝宝造成健康困扰。”
培养基中生长的菌株
什么是解决致敏问题的关键?
对于有宝宝的家庭而言,吸尘器可强劲吸除尘螨及其分泌物、排泄物及残肢,从根源上清除尘螨的营养来源,打造洁净健康的家居环境。
自2001年开始,戴森科学家就开始在微生物学实验室中研究尘螨粪便、花粉、霉菌、真菌等微小颗粒物。在微生物实验室里,戴森科学家研发出自己的尘螨培养系统——欧洲室尘螨(屋尘螨)和美洲室尘螨(粉尘螨)。为了研究如何能够高效并彻底地清除尘螨以及尘螨所带来的致敏隐患,戴森在产品研发时对尘螨灰尘进行微观研究,并进行了大量中国本地真实家居环境模拟测试。

戴森微生物实验室显微镜下观察到的尘螨形态
晾晒拍打的传统方法及许多除螨仪使用的“紫外线光照”功能,对杀死织物床褥等表面的螨虫及去除其排泄物与残肢更是效果甚微,甚至无法触及深处的过敏原。[ 央视新闻《每周质量报告》2020年7月27日节目。]
宝宝免疫系统发育尚未成熟,针对宝爸宝妈们的深层清洁需求,戴森独有的戴森Hyperdymium旋速马达和气旋技术,可以强劲吸力高效吸除表面及缝隙内的大小颗粒;凭借气旋优异的尘气分离能力,还可确保在过滤尘垢时气道不会堵塞,造成吸力衰减。
戴森无绳吸尘器配备的电动床褥吸头可深入织物纤维,尼龙刷条可深度清洁爬行垫、被子、枕头中肉眼不可见的尘螨相关过敏原5,及尘螨赖以为食的皮屑、食物碎屑,切断尘螨营养源,抑制其繁殖和再生长,除螨清洁率高达99%[ 基于通标标准技术服务(上海)有限公司在产品Max(强效)模式下进行的除螨测试结果,受制于实验条件,实验结果与实际使用可能会有不同。检测机构:通标标准技术服务(上海)有限公司。报告编号:SHES181200024574。]。
强大且高速通过的离心力能够将更多大大小小的灰尘分离并甩入尘桶中。直线气流的设计,将马达、集尘桶和气旋组三点一线连成直线路径,让气流贴边顺畅进入吸尘杆,以直线方式通过机身并进入气旋组,避免气流损耗,提高进气效率,确保气道畅通无阻,有助实现更优异的吸尘表现。
高效深度清洁,不仅要求清洁工具吸力强劲,还需要避免二次污染危害宝宝健康。戴森V11无绳吸尘器搭配先进的整机密封和多重过滤系统,锁住99.99%小至0.3微米的微尘[ 基于ASTM F1977-04测试标准。在符合规定的测试条件下,由第三方独立实验所进行的测试。测定真空吸尘器系统初始部分过滤效率的标准试验方法,在MAX(BOOST/强效)模式下,通过整个吸尘器系统对非连续直径的6种颗粒物的过滤效率分析(0.3微米、0.5微米、0.7微米、1.0微米、2.0微米以及3.0微米以上的颗粒),整个测试过程吸尘器系统置于固定状态,通过计数上游粒子与下游粒子数量用于分析及获得结果。测试环境:空气温度(21.1℃±2.8℃)及湿度区间35%至55%。检测机构:通标标准技术服务(上海)有限公司,报告号:SHES1902011977C74。],排出洁净空气,避免二次污染。
针对宝宝喜欢探索周围环境的天性,戴森V11系列无绳吸尘器拥有戴森史上最强劲吸力[ 基于IEC 62885-2标准的条款5.8,在强效模式下进行的吸力测试,对比戴森前几代无绳吸尘器。基于外部与内部实验室测试,实际结果会因具体情况而不同。]、最全吸头配置[ 对比戴森前几代无绳吸尘器。]、最长续航时间、智能吸尘等特性,帮助全方位清洁宝宝常活动的区域,例如爬行垫、积木桌、地板、沙发、床褥等,也可以轻松清洁天花板、缝隙处等易忽略的角落。

戴森V11 Absolute Extra无绳吸尘器(左)及全新黑色限量款戴森V11 Complete Extra无绳吸尘器(右)
为深入中国城市家庭对易被忽视的灰尘及过敏原5开展研究,戴森已到访成都、北京、杭州、深圳等地,旨在更好地为消费者提供全方位的居家清洁解决方案。
关于戴森微信生态圈
戴森微信生态圈建立于2015年,包含戴森公众号与戴森小程序,为戴森用户提供品牌、产品、科技资讯及会员服务。通过戴森小程序前往戴森官方微信旗舰店,可了解并购买戴森全线产品、配件及微信渠道限定产品,同时提供使用指南、全套售后、会员专享等服务,开启健康科技新生活。
关于戴森
戴森成立于1993年,最初在英国巴斯(Bath)附近的一栋马车房内办公,多年来持续发展壮大,成为一家全球性科技公司。戴森在英国、马来西亚、新加坡和菲律宾设有工程及测试运营机构。
戴森全球直接雇员总数超过16,000人,其中包括6,000多名工程师与科学家;戴森全球各地的研发团队致力于持续研发固态电池,高速数码马达,视觉系统,机器学习技术及人工智能方面的创新技术。戴森拥有全英规模领先的机器人技术研发团队,除了不断壮大的公司自有团队外,位于英国伦敦帝国理工学院(Imperial College London)的戴森机器人实验室(Dyson Robotics Lab)也在不断开展长期研究项目。
更多信息
欲了解更多信息,请通过以下方式联系:yuejiao.zhang@dyson.com
网址:深圳家庭健康“宝”典,致敏主因并非尘螨本身 https://www.jiaju82.com/news-view-id-728321.html

